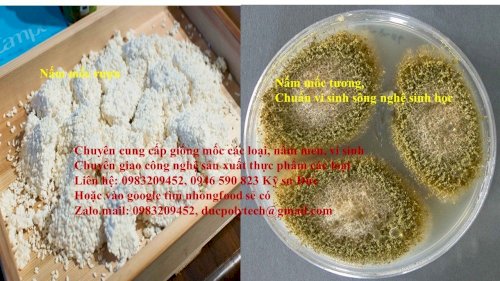

Bán Meo Làm Tương Hột
10 triệu
89/1 Ds 8 Tăng Nhơn Phú B Quận 9
Các loại mốc thường thấy:
· Nấm mốc Aspergillus oryzae sinh ra các enzym amylaz, invertaz, maltoz, proteaz và cataz có khả năng phân giải tinh bột, protein thành đường, acid amin. Nấm mốc Aspergillus oryzae là tác nhân chủ yếu lên men trong sản xuất nước tương theo phương pháp vi sinh vật. Trong công nghiệp người ta nhân giống nấm mốc này để sản xuất tương.
Nấm Aspergillus còn gọi là mốc tương. Sợi nấm có vách ngăn, cuống mang bào tử bụi phồng lên ở ngọn. Các chuổi bào tử bụi từ đầu phồng mọc tỏa khắp mọi hướng. Bào tử bụi có thể màu vàng (Aspergillus flavus), màu đen (Aspergillus niger). Nấm Aspergillus oryzae là loài mốc chính trong quá trình chế tạo tương và tương do Aspergillus oryzae lên men ngon hơn các tương khác vì loại mốc này có khả năng biến đổi tinh bột của gạo nếp thành đường làm cho tương có vị ngọt. Hai loài không độc làm tương là Aspergillus oryzae và Aspergillus sojae có hình thái và màu sắc rất giống với 2 loài rất nguy hiểm là Aspergillus flavus và Aspergillus parasiticus sản sinh ra độc tố Aflatoxin gây bệnh ung thư.
Nấm mốc làm tương Aspergillus Oryzae – Kỹ sư Đức
Sản xuất chao, tương các loai,....

HẾT HẠN
| Mã số : | 16245305 |
| Địa điểm : | Toàn quốc |
| Hình thức : | Cần bán |
| Tình trạng : | Hàng mới |
| Hết hạn : | 09/04/2021 |
| Loại tin : | Thường |
Gợi ý cho bạn













Bình luận